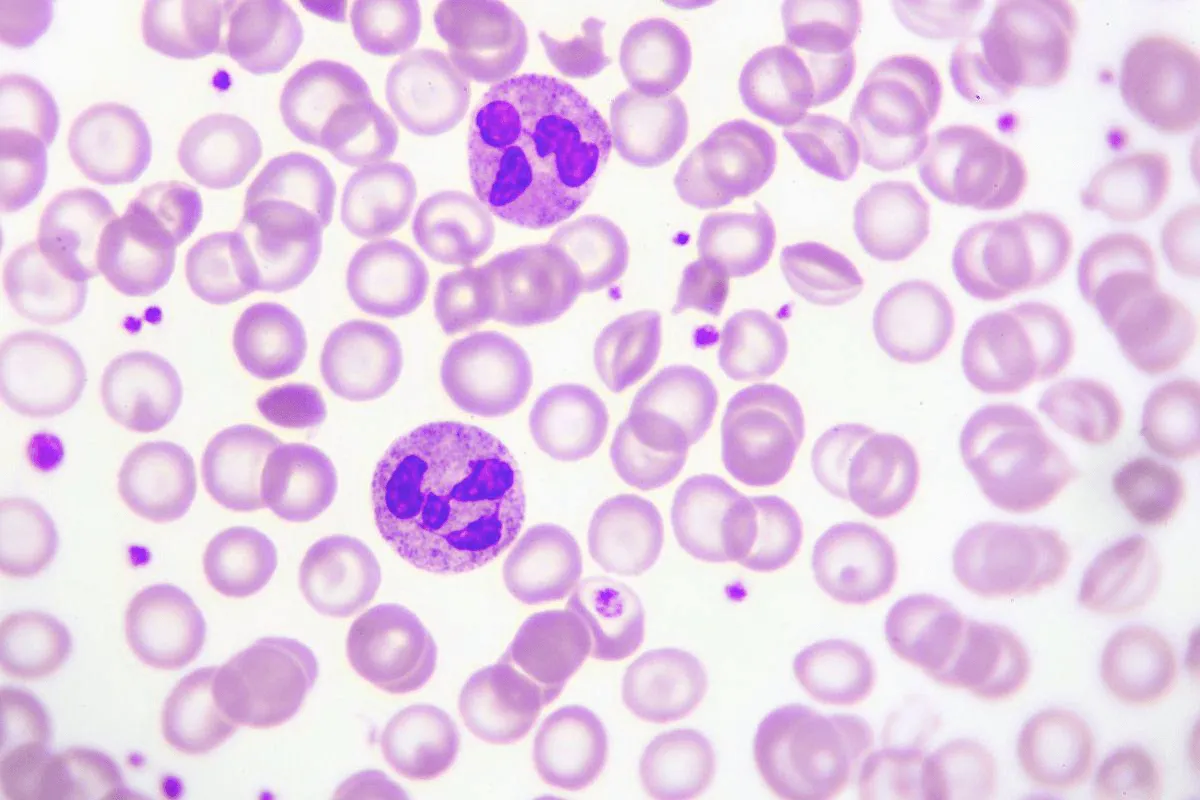
Zdjęcie Co oznacza neut w badaniu krwi? Zrozumienie ich roli i normy

Neutrofile (oznaczane jako NEU lub NEUT) to kluczowy element naszego układu odpornościowego. Stanowią one największą grupę białych krwinek, odpowiadającą za ochronę organizmu przed infekcjami bakteryjnymi oraz innymi patogenami. Ich poziom jest często badany w ramach morfologii krwi, co pozwala na ocenę stanu zdrowia pacjenta. Wyniki tego badania mogą dostarczyć cennych informacji o funkcjonowaniu układu odpornościowego oraz wskazać na potencjalne problemy zdrowotne.
Warto wiedzieć, że norma dla neutrofili u dorosłych wynosi zazwyczaj 1,8–7,2 × 10³/µl. Poziomy poniżej tej normy mogą sugerować neutropenię, natomiast wartości powyżej mogą wskazywać na neutrofilię. Zmiany w liczbie neutrofili mogą być wynikiem różnych stanów, takich jak infekcje, choroby autoimmunologiczne, a nawet nowotwory. Dlatego tak ważne jest, aby interpretacja wyników była przeprowadzana przez lekarza.
Kluczowe wnioski:
- Neutrofile to najliczniejsza grupa białych krwinek, stanowiąca 50-70% wszystkich leukocytów.
- Norma dla neutrofili u dorosłych wynosi 1,8–7,2 × 10³/µl.
- Poziomy poniżej 1,5 × 10³/µl oznaczają neutropenię, a powyżej 8,0 × 10³/µl – neutrofilię.
- Nieprawidłowe poziomy neutrofili mogą wskazywać na stany zapalne, infekcje, choroby autoimmunologiczne lub nowotwory.
- Interpretacja wyników powinna być przeprowadzona przez lekarza, aby zrozumieć ich znaczenie w kontekście zdrowia pacjenta.
Co to są neutrofile i ich rola w organizmie?
Neutrofile to najliczniejsza grupa białych krwinek, które odgrywają kluczową rolę w naszym układzie odpornościowym. Stanowią one około 50-70% wszystkich leukocytów w organizmie. Ich główną funkcją jest ochrona przed infekcjami bakteryjnymi oraz innymi patogenami. Neutrofile są produkowane w szpiku kostnym i uwalniane do krwiobiegu, gdzie krążą i monitorują stan zdrowia organizmu.
Te komórki krwi są niezbędne w odpowiedzi immunologicznej, ponieważ szybko reagują na zagrożenia, takie jak infekcje. Kiedy organizm wykryje obecność bakterii lub wirusów, neutrofile są jednym z pierwszych elementów, które docierają do miejsca infekcji, aby zneutralizować zagrożenie. Ich zdolność do fagocytozy, czyli pochłaniania i niszczenia patogenów, jest kluczowa w walce z infekcjami.
Zrozumienie funkcji neutrofili w systemie odpornościowym
Neutrofile działają na kilka sposobów, aby bronić organizm przed chorobami. Po pierwsze, są one zdolne do wykrywania i przyciągania się do miejsc, gdzie występują patogeny. Używają chemicznych sygnałów, aby zlokalizować źródło infekcji, co pozwala im na szybkie reagowanie. Po dotarciu na miejsce, neutrofile mogą zabić bakterie poprzez wydzielanie substancji chemicznych, które niszczą ich ściany komórkowe.
Po drugie, neutrofile są także odpowiedzialne za proces zapalny. W momencie, gdy neutrofile dostają się do miejsca infekcji, uwalniają różne cytokiny, które pomagają w aktywacji innych komórek układu odpornościowego. To współdziałanie jest kluczowe dla efektywnej odpowiedzi immunologicznej, a neutrofile pełnią rolę koordynatorów tej reakcji. Dzięki nim, organizm jest w stanie skutecznie walczyć z infekcjami i przyspieszyć proces gojenia.
Jak neutrofile chronią przed infekcjami i chorobami?
Neutrofile odgrywają kluczową rolę w obronie organizmu przed różnymi patogenami, takimi jak bakterie, wirusy i grzyby. Kiedy do organizmu dostają się niebezpieczne mikroorganizmy, neutrofile są jednymi z pierwszych komórek, które reagują na zagrożenie. Ich zdolność do fagocytozy pozwala im na pochłanianie i niszczenie patogenów, co jest kluczowe dla zapobiegania rozprzestrzenieniu się infekcji.
Na przykład, podczas infekcji bakteryjnej, takiej jak zapalenie płuc, neutrofile migrują do miejsca zakażenia, gdzie aktywnie eliminują bakterie, takie jak Streptococcus pneumoniae. Dodatkowo, w przypadku infekcji grzybiczej, neutrofile mogą zwalczać patogeny takie jak Candida albicans, które mogą prowadzić do poważnych problemów zdrowotnych, szczególnie u osób z osłabionym układem odpornościowym. Ich szybka reakcja i zdolność do współpracy z innymi komórkami układu odpornościowego są kluczowe dla skutecznej walki z infekcjami.
- Streptococcus pneumoniae – bakteria wywołująca zapalenie płuc, na którą neutrofile reagują natychmiast.
- Escherichia coli – patogen odpowiedzialny za zakażenia układu moczowego, który również jest zwalczany przez neutrofile.
- Candida albicans – grzyb, który może powodować infekcje u osób z osłabionym układem odpornościowym, a neutrofile pomagają w jego eliminacji.
Jakie są prawidłowe wartości neutrofili u dorosłych?
Prawidłowe wartości neutrofili u dorosłych wynoszą zazwyczaj od 1,8 do 7,2 × 10³/µl. Wartości te mogą się różnić w zależności od wielu czynników, takich jak wiek, płeć, a także stan zdrowia pacjenta. Na przykład, u osób starszych poziom neutrofili może być nieco niższy, podczas gdy u kobiet w ciąży może występować ich zwiększona liczba. Dlatego ważne jest, aby wyniki badań były interpretowane w kontekście ogólnego stanu zdrowia pacjenta.
| Wiek | Prawidłowy zakres neutrofili (× 10³/µl) |
|---|---|
| Dorośli (18-65 lat) | 1,8 - 7,2 |
| Osoby starsze (powyżej 65 lat) | 1,5 - 6,5 |
| Kobiety w ciąży | 2,0 - 8,0 |
Co oznaczają nieprawidłowe poziomy neutrofili?
Neutropenia, czyli niski poziom neutrofili, może wskazywać na różne problemy zdrowotne. Może być spowodowana przez infekcje wirusowe, które hamują produkcję neutrofili w szpiku kostnym, lub przez choroby autoimmunologiczne, takie jak toczeń. Niski poziom neutrofili zwiększa ryzyko infekcji, ponieważ organizm jest mniej zdolny do obrony przed patogenami. Osoby z neutropenią powinny być szczególnie ostrożne i regularnie monitorować swój stan zdrowia.
Z drugiej strony, neutrofilia, czyli podwyższony poziom neutrofili, może być wynikiem reakcji organizmu na infekcje bakteryjne, stany zapalne lub stres. W takich przypadkach neutrofile są mobilizowane, aby zwalczać infekcje i wspierać procesy zapalne. Jednakże, długotrwała neutrofilia może wskazywać na poważniejsze schorzenia, takie jak nowotwory, dlatego konieczna jest konsultacja z lekarzem w celu dalszej diagnostyki.
Jak lekarze interpretują wyniki neutrofili w badaniach krwi?
Interpretacja wyników neutrofili przez lekarzy jest kluczowym elementem oceny stanu zdrowia pacjenta. Neutrofile są istotnym wskaźnikiem, który pomaga w diagnozowaniu różnych schorzeń. Lekarze analizują poziomy neutrofili w kontekście innych wyników badań oraz objawów klinicznych pacjenta. Taki holistyczny sposób podejścia pozwala na dokładniejszą ocenę i zrozumienie, co może się dziać w organizmie.
Rola neutrofili w diagnozowaniu stanów zapalnych i infekcji
Wysoki poziom neutrofili często wskazuje na obecność stanu zapalnego lub infekcji bakteryjnej. Na przykład, u pacjentów z zapaleniem płuc, poziom neutrofili może być znacznie podwyższony, co sugeruje aktywną reakcję organizmu na infekcję. W takich przypadkach lekarze mogą zlecić dodatkowe badania, aby określić rodzaj patogenu i odpowiednio dostosować leczenie. Innym przykładem może być zapalenie wyrostka robaczkowego, gdzie również obserwuje się zwiększenie liczby neutrofili jako odpowiedź na infekcję.
Neutrofile odgrywają również istotną rolę w diagnozowaniu chorób autoimmunologicznych. Na przykład, w przypadku tocznia rumieniowatego, lekarze mogą zauważyć zmiany w poziomach neutrofili, które mogą wskazywać na zaostrzenie choroby. Zrozumienie tych wartości jest kluczowe dla podejmowania decyzji terapeutycznych i monitorowania stanu pacjenta. Warto zaznaczyć, że każdy przypadek jest inny, a interpretacja wyników powinna być zawsze dostosowana do konkretnej sytuacji klinicznej.
Jak zmiany w poziomie neutrofili wpływają na decyzje medyczne?
Wahania poziomu neutrofili mają istotny wpływ na decyzje medyczne i zarządzanie pacjentem. Na przykład, gdy poziom neutrofili jest podwyższony, lekarze mogą podejrzewać obecność infekcji bakteryjnej lub stanu zapalnego. W takich przypadkach często zleca się dodatkowe badania, aby zidentyfikować konkretny patogen i dostosować leczenie. Przykładem może być pacjent z zapaleniem płuc, u którego stwierdzono wysoką liczbę neutrofili. Lekarz może zdecydować o wprowadzeniu antybiotykoterapii, aby skutecznie zwalczyć infekcję.
Natomiast w przypadku neutropenii, czyli obniżonego poziomu neutrofili, lekarze muszą być szczególnie ostrożni. Niski poziom neutrofili zwiększa ryzyko zakażeń, co może wymagać zmiany w podejściu do leczenia. Na przykład, jeśli pacjent z chorobą nowotworową przechodzi chemioterapię i wykazuje neutropenię, lekarz może zalecić stosowanie leków stymulujących produkcję neutrofili lub wprowadzenie ścisłej kontroli infekcji, aby chronić pacjenta przed poważnymi komplikacjami. Takie decyzje są kluczowe dla zapewnienia bezpieczeństwa i skuteczności leczenia pacjenta.
Czytaj więcej: Przedmiot badań co to? Klucz do skutecznych badań naukowych
Jak monitorowanie poziomu neutrofili wspiera profilaktykę zdrowotną?
Regularne monitorowanie poziomu neutrofili może być kluczowym elementem w profilaktyce zdrowotnej, zwłaszcza u osób z grupy ryzyka, takich jak pacjenci onkologiczni czy osoby z chorobami autoimmunologicznymi. Wprowadzenie systematycznych badań krwi pozwala na wczesne wykrywanie nieprawidłowości, co może prowadzić do szybszego wdrożenia odpowiednich działań medycznych. Na przykład, pacjenci, którzy regularnie kontrolują poziom neutrofili, mogą uniknąć poważnych infekcji poprzez wcześniejsze dostosowanie terapii lub wprowadzenie dodatkowych środków ochronnych.
W przyszłości technologia może jeszcze bardziej usprawnić monitorowanie poziomu neutrofili. Rozwój inteligentnych urządzeń medycznych oraz aplikacji mobilnych, które umożliwiają pacjentom samodzielne monitorowanie ich wyników, może zrewolucjonizować podejście do zarządzania zdrowiem. Takie rozwiązania pozwolą na bieżąco śledzić zmiany w poziomie neutrofili i automatycznie informować lekarzy o niepokojących wynikach, co przyczyni się do bardziej spersonalizowanej opieki zdrowotnej oraz szybszej reakcji na potencjalne zagrożenia zdrowotne.




